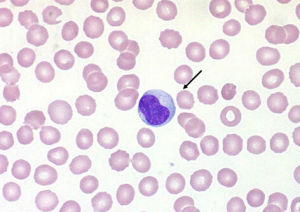
空泡變性

變性嚴重者,小水泡相互融合成大水泡,細胞核懸於中央,或被擠於一側,細胞形體顯著腫大,胞漿空白,外形如氣球獎,所以又稱為 氣球樣變。
相關詞條
-
變性
根據損傷輕重程度不同,分為可復性損傷和不可復性損傷兩大類,變性一般為可復性損傷,而細胞死亡則為不可復性損傷。變性(degeneration)系指細胞或間...
名詞解釋 生物變性 蛋白質的變性 面臨問題 -
變性[物體的性質發生改變]
變性是物體的性質發生改變,物質屬性的自然(主動)或非自然(被動)改變。廣義上包括化學、生物甚至人類的性別。
名詞解釋 生物變性 蛋白質的變性 面臨問題 -
空泡蝶鞍綜合徵
空泡蝶鞍綜合徵 emptysellasyndrome 系因鞍隔缺損或垂體萎縮,蛛網膜下腔在腦脊液壓力衝擊下突入鞍內,致蝶鞍擴大,垂體受壓而產生的一系列臨...
病因 臨床表現 診斷說明 鑑別診斷 治療說明 -
空泡蝶鞍綜合症
蝶骨在顱中窩中間部分高起,形如馬鞍的骨結構。蝶鞍中央凹陷叫垂體窩,容納腦垂體。正常情況下,蝶鞍與腦垂體之間緊密相貼,幾乎沒有空隙。當各種病理因素導致蝶鞍...
定義 發病原因 表現及診斷 檢查 並發病 -
額顳葉變性
額顳葉變性(frontotemporal lobe degeneration, FTLD)是大腦局限性額葉和顳葉變性萎縮為特徵的中樞神經系統退行性疾病,...
疾病介紹 病理生理 發病原因 疾病分類 臨床表現 -
脂肪變性
脂肪變性是細胞漿內甘油三酯(中性脂肪)的蓄積稱為脂肪變或脂肪變性。常因營養障礙、感染、中毒和缺氧等引起。多發生於代謝旺盛、耗氧多的組織,如肝細胞、心肌纖...
-
格子狀角膜變性
格子狀角膜變性(lattice corneal dystrophy)為一種雙眼對稱性角膜基質出現格線狀混濁、視力損害較重的遺傳性角膜病變。
介紹 疾病名稱 英文名稱 別名 分類 -
退化變性
退化變性(degeneration)簡稱退變,是細胞自然衰老的現象。當局部組織病理性損傷、炎症及惡變時,加快了上皮細胞的退化變性。